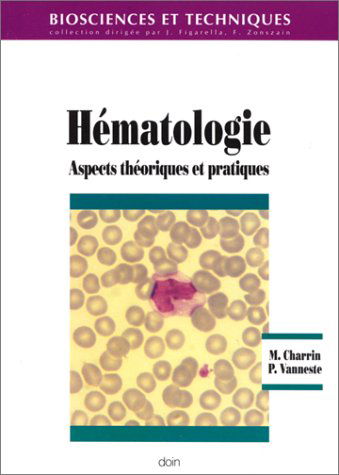
Hématologie : aspects théoriques et pratiques

- Retour
- Tous les ouvrages
- Théâtre
- Littérature française
- Poésie
- Livres de référence
- Littérature anglaise
- Romans historiques
- Littérature humoristique
- Récits de voyages
- Littérature italienne
- Antiquité
- Correspondances et mémoires
- Autres littératures étrangères
- Littérature japonaise
- Littérature américaine
- Biographies
- Littérature russe
- Littérature espagnole
- Retour
- Tous les ouvrages
- Castor poche junior
- Castor benjamin-cadet
- Nathanpoche 6-8 ans
- Première Bibliothèque Rose
- Bibliothèque Rose
- Casterman
- Pocket jeunesse
- Belles histoires
- Bayard-Je bouquine
- Folio junior
- Livre de poche jeunesse
- Bibliothèque verte
- Nathanpoche
- Folio benjamin
- Folio cadet
- J'aime lire
- La cabane magique
- Retour
- Tous les ouvrages
- Histoire de l'art
- Peinture
- Techniques de l'art
- Musique
- Danse
- Photographie
- Architecture
- Design
- Théâtre
- Musées et expositions
- Art mural - Graffitis - Tags
- Cinéma
- Beaux livres
- Mode
- Cirque
- Marché de l'art
- Art mondial
- Arts populaires
- Critique d'art
- Sculpture
- Les Classiques de l'art
- Retour
- Tous les ouvrages
- Médecine
- Sciences pour tous
- Agriculture - Agroalimentaire
- Mathématiques
- Sciences de la vie - Biologie - Génétique
- Sciences de la terre - Eau - Environnement
- Histoire des sciences
- Astronomie
- Bâtiment - Travaux publics - Matériaux
- Personnages scientifiques
- Physique - Sciences de la matière
- Techniques industrielles
- Chimie
- Sciences vétérinaires
- Artisanat
- Chaos
- Retour
- Tous les ouvrages
- Bouddhisme
- Islam
- Catholicisme
- Théologie
- Mysticisme
- Religion et société
- Bible
- Dictionnaires et encyclopédies
- Histoire des religions
- Protestantisme
- Hindouisme
- Judaïsme
- Art religieux
- Christianisme
- Sagesses orientales
- Orthodoxie et Églises d'Orient
- Taoïsme et Confucianisme
- Dialogue interreligieux
- Exégèse
- Shinto
- Vaudou, chamanisme et animisme
- Paranormal et parapsychologie
- Esotérisme et Paranormal
- Kabbale, gnose et occultisme
- Franc-maçonnerie et compagnonnage
- Egypte et le Livre des Morts
- Yi King
- Feng-Shui
- Retour
- Tous les ouvrages
- Auteurs initiés et magie en littérature
- Mythes et légendes
- Astrologie et arts divinatoires
- Kabbale, gnose et occultisme
- Magie et sorcellerie
- Franc-maçonnerie et compagnonnage
- Rêves, symboles et runes
- Ouvrages de référence
- Rose-Croix, Cathares et Templiers
- Magnétisme, radiesthésie et sourciers
- Au-delà, spiritisme et réincarnation
- Feng Shui
- Paranormal et parapsychologie
- Extraterrestres et ovnis
- Nostradamus et prophéties
- Alchimie
- Celtes et druides
- Théosophie
- Anges et angéologie
- Lieux spirituels
- Egypte
- Vampires, fantômes, fées et autres créatures
- Cristaux, pierres et couleurs
- Voyage astral
- Atlantide, pyramides et grandes énigmes
- New Age
- Hypnose et télépathie
- Exorcisme
- Mysticisme
- Retour
- Tous les ouvrages
- Shôjo manga (sentimental)
- Fantastique
- Manhwa (manga coréen)
- Science-fiction et Terreur
- Aventure
- Littérature, Histoire et Philosophie
- Arts martiaux et Combats
- Heroïc-Fantasy
- Érotisme (Hentai)
- Artbooks, livres techniques et généralités
- Humour
- Thriller et Suspense
- Sports
- Histoires courtes et One shots
- Retour
- Tous les ouvrages
- Programmation et langages
- Internet
- Entreprise
- Multimédia et graphisme
- Matériel
- Systèmes d'exploitation
- Jeux
- Bureautique et publication
- Bases de données
- Réseaux et télécommunication
- Linux et logiciels libres
- Sécurité informatique
- Intelligence artificielle
- Intranet
- Certifications
- Cyberculture
- Retour
- Tous les ouvrages
- Bases de la cuisine
- Desserts
- Cuisine au quotidien
- Cuisines du monde
- Cafés, thés, chocolats
- Gastronomie
- Vins
- Art de la table, Fêtes et Réceptions
- Légumes
- Poissons et Fruits de mer
- Fromages
- Entrées
- Alcools et spiritueux
- Cuisine de saison
- Cuisines régionales
- Pâtes, riz
- Cuisiniers vus à la télé
- Viandes, volailles, gibiers
- Beaux livres
- Régime spécial
- Retour
- Tous les ouvrages
- Maladies et dépendances
- Alimentation, régimes et diététique
- Beauté, forme et détente
- Guides pratiques
- Femmes
- Hommes
- Médecines douces
- Santé des femmes
- Santé des hommes
- Beauté, soins et style
- Psychologie et psychanalyse
- Dépendances et guérison
- Vieillissement
- Santé des enfants
- Santé mentale
- Exercice et fitness
✅ Et hop, votre produit a été ajouté au panier
✅ Ajouté au panier
Ces livres pourraient aussi vous plaire:




Analyses biologiques, sujets de bts corrigés
Martine Charrin
Nos options de livraison
 Offerte
Offerte
Livraison en point relais

Livraison sous 2 à 5 jours
NOTRE CONSEIL VERT
Lors des livraisons en point relais, les émissions de CO2 sont le plus souvent moins importantes grâce au regroupement d'un grand nombre de colis dans un même camion pour un seul point de livraison.
1,99 €
Livraison suivie à domicile
Livraison sous 3 à 5 jours
Livraison offerte à partir de 19€
En savoir plus sur nos options de livraison et leur impact carbone
Tout savoir sur l'état des livres d'occasion
Cet ouvrage couvre l'ensemble des disciplines scientifiques de l'examen du BTS Analyses biologiques : mathématiques, physique et chimie, biochimie, biologie humaine, microbiologie, virologie, immunologie, hématologie, histologie, parasitologie.
Les sujets de 1995 à 2000 sont présentés et corrigés. Les corrections sont détaillées et les explications font souvent l'objet de rappels non exigés des candidats lors de l'examen.
Cet ouvrage permet ainsi aux étudiants de réviser tous les points du programme et de se préparer efficacement à l'examen.
Il est destiné aux étudiants préparant le BTS Analyses biologiques et à ceux préparant le DUT Biologie appliquée, option Analyses biologiques et biochimiques, ou le DETAB.
| Edition | Doin |
| Dimension | 18 X 24 X 1.4 |
| Auteur | Martine Charrin |
| Nombre de pages | 260 |
| ISBN | 9782704010813 |
| Date de publication | 2001 |
| Poids (g) | 460 |
| Reliure | Broché |
Article de seconde main contrôlé
Livraison offerte en point relais
Livré à partir du 18 février
Voir nos options de livraison
Cet ouvrage couvre l'ensemble des disciplines scientifiques de l'examen du BTS Analyses biologiques : mathématiques, physique et chimie, biochimie, biologie humaine, microbiologie, virologie, immunologie, hématologie, histologie, parasitologie.
Les sujets de 1995 à 2000 sont présentés et corrigés. Les corrections sont détaillées et les explications font souvent l'objet de rappels non exigés des candidats lors de l'examen.
Cet ouvrage permet ainsi aux étudiants de réviser tous les points du programme et de se préparer efficacement à l'examen.
Il est destiné aux étudiants préparant le BTS Analyses biologiques et à ceux préparant le DUT Biologie appliquée, option Analyses biologiques et biochimiques, ou le DETAB.
| Edition | Doin |
| Dimensions (L x H x E, cm) | 18 X 24 X 1.4 |
| Auteur | Martine Charrin |
| Nombre de pages | 260 |
| ISBN | 9782704010813 |
| Date de publication | 2001 |
| Poids (g) | 460 |
| Reliure | Broché |
Article de seconde main contrôlé
Livraison offerte en point relais
Livré à partir du 18 février
Voir nos options de livraison
Votre achat c'est :
Livraison rapide et incluse Livraison rapide et incluse
Vous recevrez votre commande dans les 3 à 5 jours.
+3 millions de clients +3 millions de clients
Nous ont déjà fait confiance depuis 2008.
Votre satisfaction est notre priorité
Sécurité Sécurité
Soyez rassurés : les transactions sont 100% sécurisées.
Un geste solidaire Un geste solidaire
Collecte de vos livres à domicile
Votre achat c'est :
Ces livres pourraient aussi vous plaire:






Donner ou revendre mes livres
Nous reprenons gratuitement vos livres à Paris, Lyon, Lille, Nantes, Bordeaux, Madrid, Strasbourg, Toulouse et leurs environs.
Donnez une seconde vie à vos livres !
DON ou VENTE de vos livres :
nous avons forcément une solution qui vous conviendra !
Gratuit
Simple et rapide
Engagé et français
Livres du même auteur:
Pour tout autre commentaire ou question, contactez-nous.
Recevez des inspirations littéraires, nos bons plans à petit prix et nos actus pour démocratiser l’occasion 🤍
Votre e-mail servira uniquement à vous envoyer la newsletter Recyclivre et ne sera jamais communiqué à un tiers. Vous pourrez vous désabonner en un clic à tout moment.

Avis des lecteurs Recyclivre